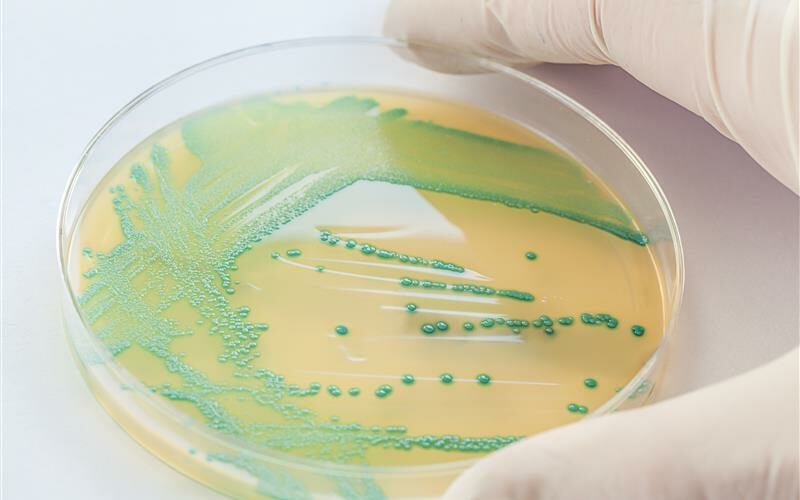
scientist-hand-holding-petri-dish-with-bacteria-2025-10-03-08-44-33-utc

Une thèse n’est pas une simple poursuite d’études
mais un premier emploi de chercheur, souvent sous contrat de trois ans, au cœur de projets innovants associant recherche publique et acteurs privés.Elle peut être réalisée dans un laboratoire académique, mais aussi dans le cadre d’une thèse CIFRE (Convention Industrielle de Formation par la Recherche), qui associe un doctorant, une entreprise et un laboratoire de recherche autour d’un projet commun.
Bordeaux Sciences Agro dispose de nombreux partenariats avec le secteur privé (coopératives, instituts techniques, entreprises agroalimentaires, pôles de compétitivité comme Agri Sud-Ouest Innovation ou Xylofutur), qui facilitent la mise en place de thèses CIFRE et le développement de projets de recherche appliquée au plus près des besoins des filières.
Les ingénieurs-docteurs formés à Bordeaux Sciences Agro occupent des postes à fort impact scientifique et sociétal, dans la recherche publique (INRAE, CNRS, universités) comme dans l’innovation privée (R&D, conseil, start-ups).
Actuellement 6% des diplômés de l’école poursuivent en doctorat dans les trois ans suivant leur diplôme. L’objectif est d’augmenter cette proportion à 10 voir 15% dans le court / moyen terme.
Le doctorat constitue une voie d’excellence pour celles et ceux qui souhaitent contribuer activement à la transition des systèmes agricoles, alimentaires et forestiers.
Un environnement scientifique reconnu
Bordeaux Sciences Agro s’appuie sur un écosystème de recherche riche et interdisciplinaire :
- 41 scientifiques intégrés dans 14 unités de recherche partenaires.
- 127 publications en 2024 (3,09 par scientifique et par an).
- 16 thèses soutenues entre 2022 et 2024.
- 1/3 des publications cosignées avec des partenaires internationaux
Ces travaux s’articulent autour de quatre thématiques transversales :
- Agroécologie, environnement, systèmes agricoles et forestiers en transition
- Qualité des produits, transformation des aliments et impact sur la santé
- Dynamiques sociétales, économie et gouvernance des transitions
- Transition numérique des systèmes agricoles, forestiers et alimentaires
Une spécialité doctorale dédiée : le parcours Sciences Agronomiques et Forestières
Depuis 2022, Bordeaux Sciences Agro est co-porteuse de la spécialité de doctorat “Sciences agronomiques et forestières”, ouverte au sein de l’Université de Bordeaux.
Cette spécialité vise à rendre visibles et reconnues les recherches doctorales portant sur les systèmes agricoles, forestiers et environnementaux, dans toutes leurs dimensions : biologiques, écologiques, économiques et technologiques.
Elle fédère des enseignants-chercheurs et chercheurs de plusieurs unités, et s’inscrit dans trois écoles doctorales :
- Sciences et Environnements (ED SE)
- Sciences de la Vie et de la Santé (ED SVS)
- Entreprise, Économie et Société (ED EES)
Cette spécialité renforce la lisibilité du continuum licence – ingénieur – doctorat en agro-sciences et accroît l’attractivité du site bordelais pour les étudiants français et internationaux souhaitant réaliser une thèse dans le domaine des sciences agronomiques.
Les thèses y sont financées par des contrats doctoraux, des bourses CIFRE, des appels à projets régionaux ou ministériels, ou encore des coopérations internationales.


Le Parcours Recherche : accompagner et faire naître des vocations
Bordeaux Sciences Agro propose un Parcours Recherche (S5 à S10) pour accompagner les étudiants intéressés par la recherche.
L’objectif est de préparer efficacement à la poursuite en doctorat, tout en développant la curiosité scientifique, l’esprit critique et la rigueur méthodologique indispensables à toute démarche de recherche.
Ce dispositif vise aussi à accompagner les vocations existantes et à faire émerger de nouvelles envies de recherche, en donnant aux étudiants l’opportunité de découvrir la richesse des métiers scientifiques et la diversité des environnements dans lesquels ils peuvent s’épanouir.
Quelques temps forts de ce parcours :
- Séminaires “Penser demain” sur la démarche scientifique, l’éthique, la recherche non académique, etc.
- “Jeu de piste” de découverte des unités de recherche partenaires.
- Stages Recherche en laboratoires (INRAE, CNRS, Université de Bordeaux, etc.).
- Tutorat scientifique personnalisé par des enseignants-chercheurs de l’école.
- Conférences de doctorants et d’ingénieurs-chercheurs.
Un encadrement éthique et responsable
Bordeaux Sciences Agro est engagée dans une recherche intègre, transparente et socialement responsable :
- Signature de la Charte française de déontologie des métiers de la recherche et de la Déclaration de San Francisco (DORA). Lien sur page DORA
- Sensibilisation systématique à l’intégrité scientifique, à la science ouverte et à la responsabilité sociétale.
- Engagement fort pour l’open access : objectif 100 % de publications en libre accès d’ici 2030.
A noter que l’école dispose de son propre portail HAL institutionnel, hébergé par le CCSD (CNRS), offrant une vitrine claire et accessible de la recherche menée à Bordeaux Sciences Agro.
Une ouverture nationale et internationale
Nos doctorants bénéficient d’un environnement de recherche connecté au monde :
- Participation à l’École Internationale de Recherche Agreenium (EIR-A), qui favorise les mobilités et la formation interdisciplinaire.
- Implication dans l’Alliance européenne EU-GIFT, dédiée à la durabilité alimentaire et aux indications géographiques.
- Coopérations scientifiques avec des laboratoires internationaux et des partenariats industriels à l’étranger.
Des conditions d’encadrement et de financement favorables
Bordeaux Sciences Agro cofinance deux demi-bourses de thèse par an, prioritairement dans la spécialité Sciences Agronomiques et Forestières (Université de Bordeaux).
Les enseignants-chercheurs de l’école encadrent ou co-encadrent des doctorants inscrits dans plusieurs écoles doctorales (liste non exhaustive):
- Sciences et Environnements (ED SE)
- Sciences de la Vie et de la Santé (ED SVS)
- Sciences Chimiques (ED SC)
- Sciences Physiques et de l’Ingénieur (ED SPI)
Témoignage parcours recherche
Jeanne Gouis
J’ai entamé mon cursus ingénieur agronome avec l’idée de faire du conseil en élevage. Durant un module de démarche scientifique j’ai découvert des thématiques de santé et de bien-être animal abordées sous le prisme de la recherche : ça a été le déclic ! J’ai alors commencé à me renseigner sur les professions permettant de poursuivre dans ce milieu. J’avais déjà entendu parler du doctorat mais cela me paraissait assez flou à l’époque. Afin d’en apprendre plus sur le monde de la recherche et voir si c’était un milieu dans lequel je me voyais continuer, j’ai intégré le parcours recherche, ce qui m’a permis d’effectuer plusieurs stages en laboratoire, en étant accompagnée, conseillée et soutenue par plusieurs enseignants-chercheurs dans mon projet ! J’ai réalisé un premier stage d’immersion dans un laboratoire travaillant sur les domaines de la nutrition et de la neurologie sur des modèles souris. Cela a confirmé mon envie de poursuivre sur des thématiques de nutrition, de santé et de bien-être animal. Souhaitant également acquérir des compétences expérimentales, j’ai effectué mon stage de pré-spé en biologie cellulaire sur la truite arc-en-ciel. A l’issue de ce stage, j’ai commencé à envisager sérieusement la thèse après l’école d’ingénieur, dans le domaine du comportement animal. Mon stage de fin d’étude a donc porté sur les comportements alimentaires et d’anticipation de récompense de souris gestantes, avec des applications en élevage porcin. Ce stage m’a permis d’approfondir mes connaissances en comportement animal et de me former à plusieurs techniques d’analyses associées. En parallèle, j’ai postulé à plusieurs sujets de thèse et j’ai été admise sur un sujet portant sur les capacités cognitives de la poule domestique à l’égard de l’humain ! Tout au long de mes candidatures, j’ai pu de nouveau bénéficier de conseils et de soutien. Cela m’a aussi rassuré dans les démarches à suivre pour me lancer ! Ce que je retiens de ce parcours, c’est que continuer en thèse après une école d’ingénieur, c’est possible, même si ce n’est pas toujours vu comme la filière de prédilection pour un doctorat ! Il ne faut pas hésiter à postuler à des stages en unité de recherche et à des thèses !
